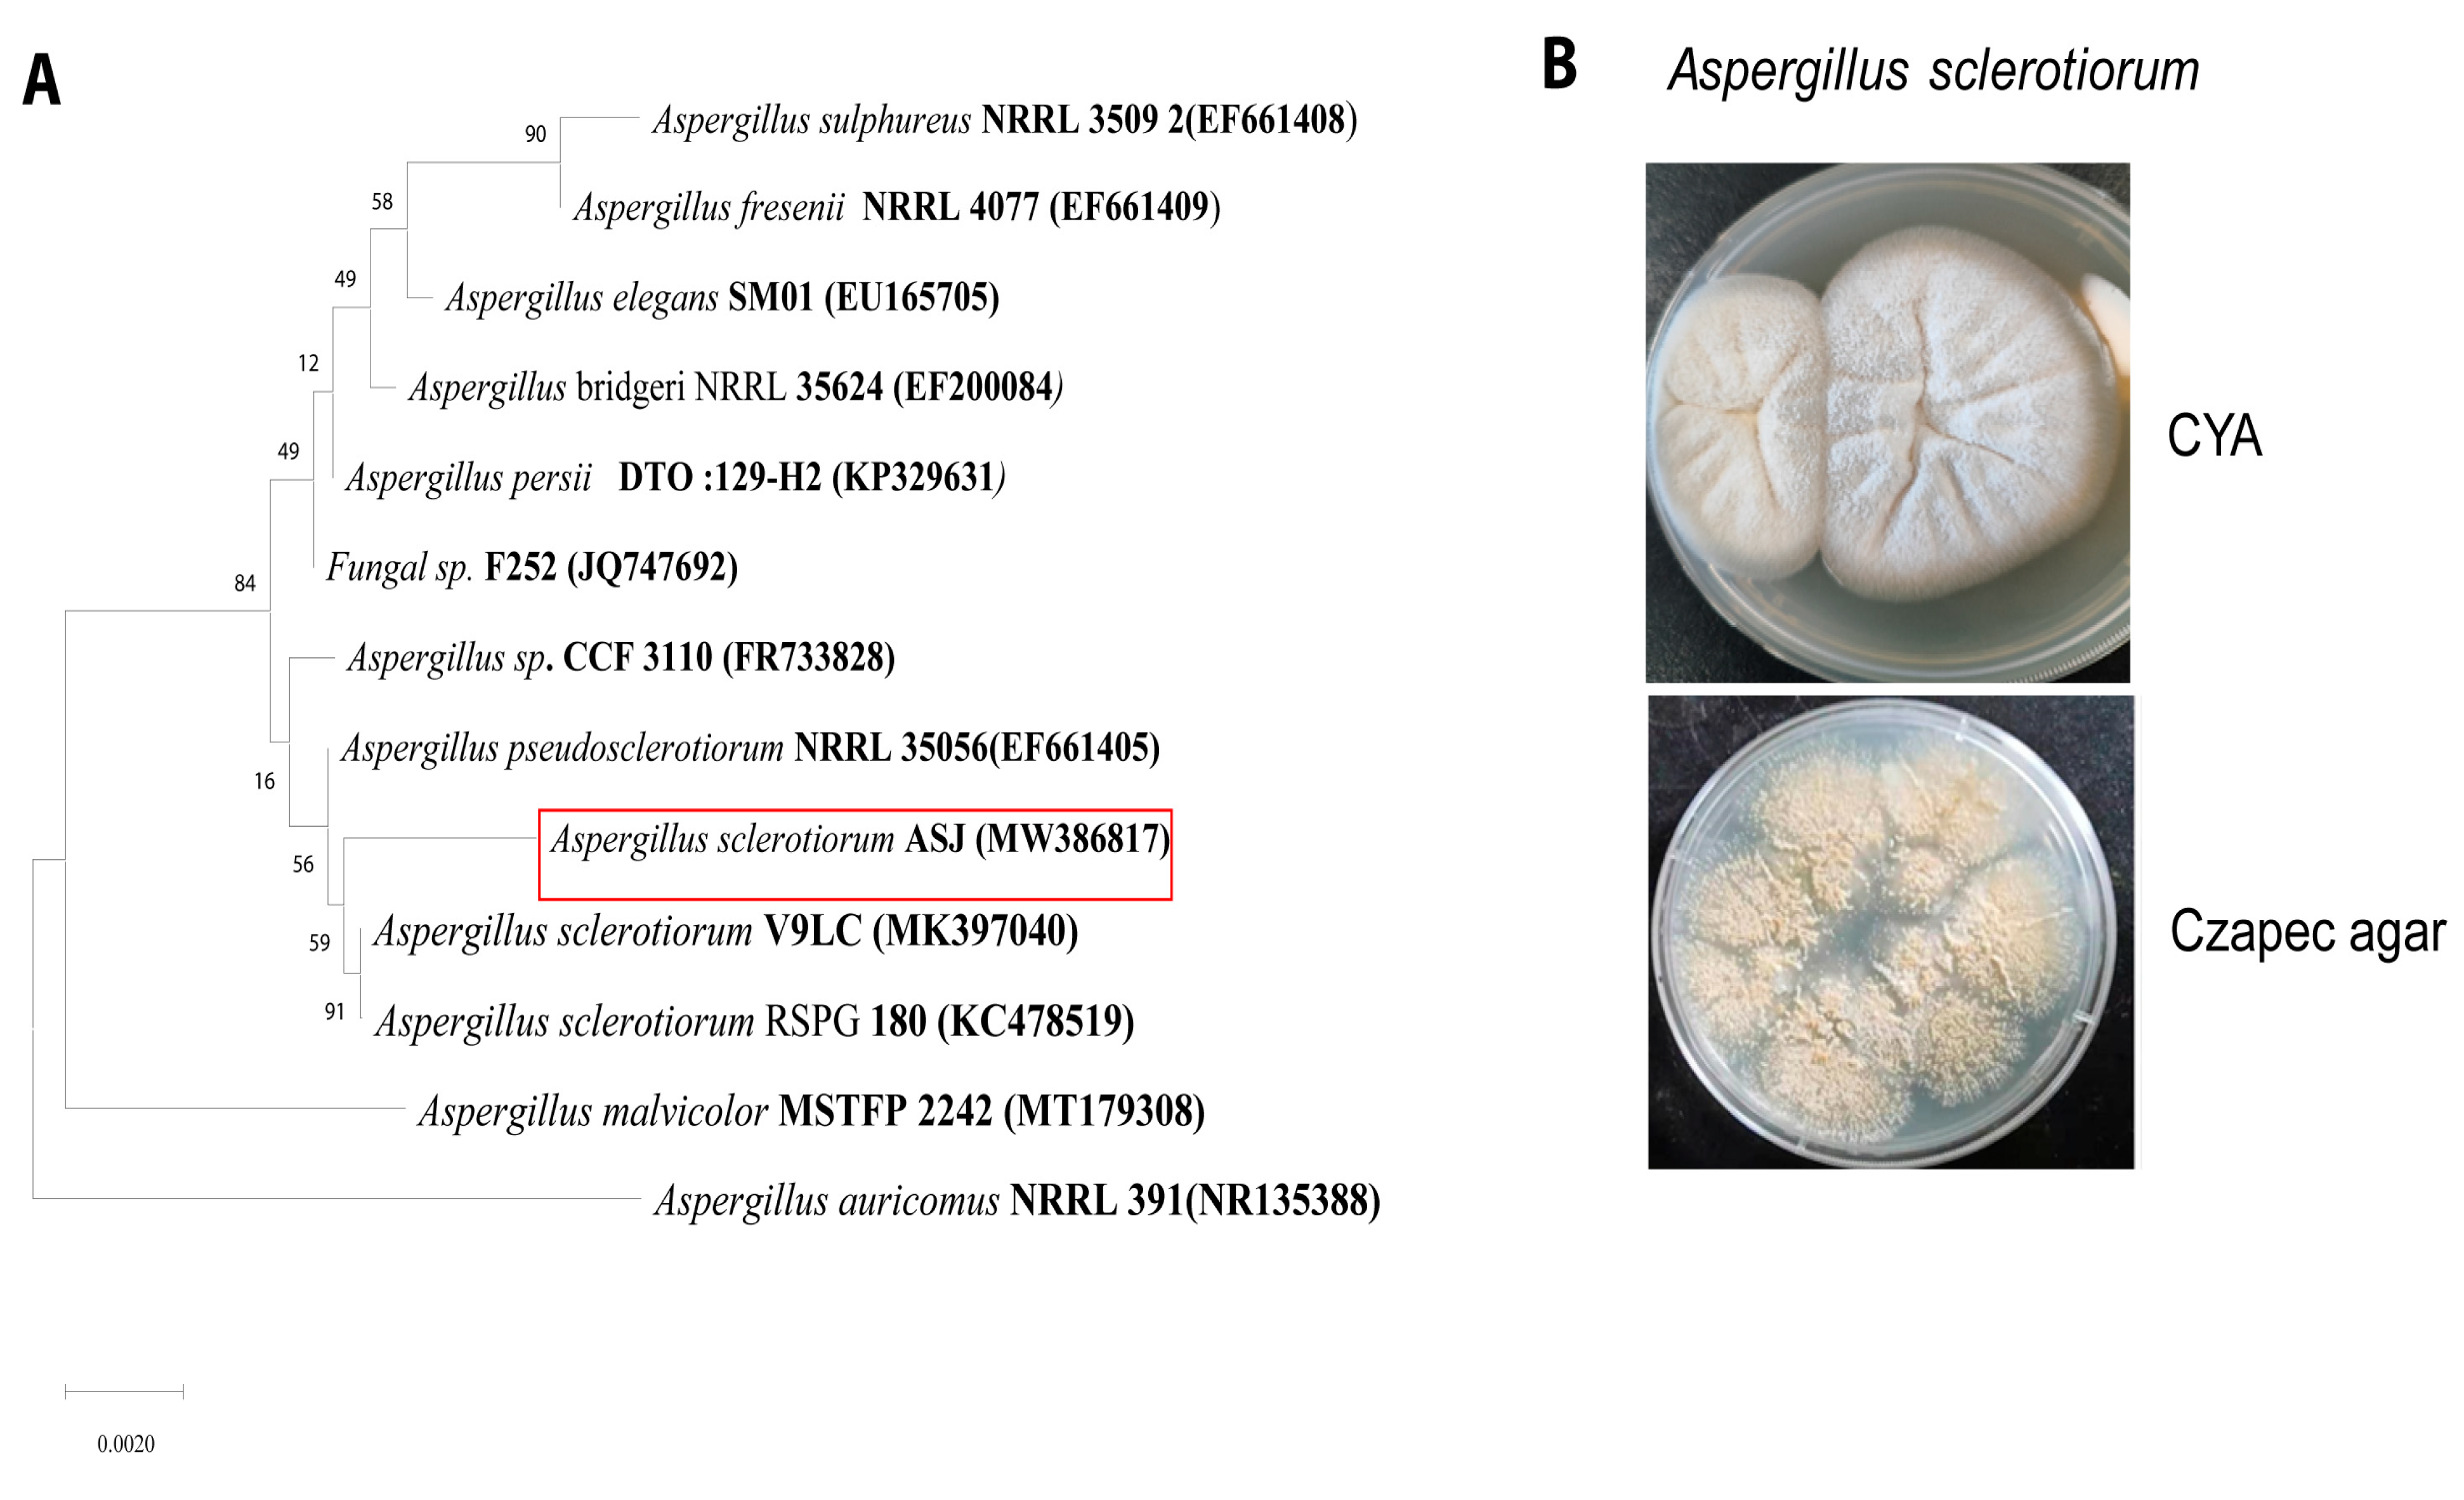
Fermentation 09 00579 g002

Abstract
In green chemistry, filamentous fungi are regarded as a kind of robust microorganism for the biotransformation of natural products. Nonetheless, the screening of microorganisms is crucial for the effective biotransformation of natural products, such as phenazine compounds. The precursor metabolite of most phenazine derivatives in Pseudomonas spp. is phenazine-1-carboxylic acid (PCA), the key constituent of shenqinmycin, widely used to control rice sheath blight in southern China. In this study, a new fungus strain Aspergillus sclerotiorum was isolated, which can efficiently convert PCA into 3-hydroxy-phenazine 1-carboxylic acid (3-OH-PCA). Moreover, an effective whole cells biotransformation system was designed by screening optimal reaction conditions and carbon sources. Hence, Aspergillus sclerotiorum exhibited desirable adaptation by the consumption of different carbon sources and maximum whole-cell biomass (10.6 g/L DCW) was obtained as a biocatalyst from glucose. Optimal conditions for whole-cell biocatalysis of PCA were evaluated, including a PCA concentration of 1120 mg/L, a pH of 7.0, a temperature of 25 °C, a rotation rate of 200 rpm, and dry cell weight of 15 g/L for 60 h; thus, 1060 mg/L of 3-OH-PCA was obtained and the conversion efficiency of PCA was 94%. Hence, the results of the repeated batch mood revealed that the biotransformation efficiency of fungus pellets reduced with each subsequent cycle, but remained stable in all five cycles with the provision of a glucose supplement. These findings present the prospect of using filamentous fungi for the whole-cell biocatalysis of phenazine in enormous amounts and the efficient production of 3-OH-PCA. Moreover, these results laid the foundation for further research to disclose the genetic-based mechanism of the strain responsible for PCA biotransformation.
1. Introduction
Biotransformation is a powerful tool for obtaining valuable products in industrial processes [1,2]. The most impressive advantage of biotransformation over other traditional synthesis techniques is the respective enzyme’s selectivity, which enantiomerically generates pure products and reduces the cost of purification. In the biotransformation reaction, purified enzymes or whole microbial cells can accomplish the reduction, oxidation, isomerization, and hydroxylation of natural products to produce novel derivatives. This process is mild, less expensive, and does not use toxic reagents or solvents, making it environmentally friendly [3,4,5]. Chemical catalysis shows too less a potent beneficial effect due to the production of toxic byproducts, and requires unfavorable and undesirable extreme conditions [6] Specifically, whole-cell biocatalysts are more industrially favorable for the production of chiral alcohols than purified enzymes [7]. The whole cell’s confined environment contains the enzymes and required cofactors, such as NADH/NADPH. However, the whole cells regenerate the cofactors, but need to be added to the pure enzyme for the continuation of the biotransformation process, which is quite expensive [8,9,10]. Thus, whole-cell biocatalysts have been considered a kind of robust and more effective way for the biocatalytic production of challenging and fine chemicals [11]. Various organisms were used to carry out the biotransformation of different natural compounds [12]. In all of them, the microbial system is more significant because of the short doubling time of biomass and can be genetically modified through well-defined techniques [13].
However, for a successful biotransformation process, the screening of microorganisms is a key step as they widen the chances of drug discovery from the industrial valuable natural products, such as phenazines compounds. Phenazines are three-ringed nitrogen-containing secreted metabolites found in environmental, industrial, and clinical settings. The precursor metabolite of mostly phenazine derivatives in Pseudomonas spp. is phenazine-1-carboxylic acid (PCA; C13H8N2O2), which has already shown great application in the agriculture sector to control various fungal diseases [14,15,16,17]. Hence, the physiological function, biosynthesis, and regulation of PCA are well understood, but the nature of microbial biotransformation is largely unknown. The biotransformation and modification of phenazine compounds are deemed risky and make agricultural settings susceptible to various diseases. Thus, the precursor metabolite PCA has been the target of various studies to screen and identify the microbes capable of its biotransformation. Fortunately, different bacterial strains have been reported and identified that can transform PCA by growing cells, such as Sphingomonas sp. DP58 [18,19], Nocardia sp. LAM0056, Rhodococcus sp. JVH1, Mycobacterium sp. DNK1213, Mycobacterium sp. CT6, and Mycobacterium sp. ATCC6841 [20,21]. In addition to bacterial biotransformation, some studies have demonstrated PCA modification by growing cells of filamentous fungi [22,23]. However, the derivatives of PCA portrayed more specific antimicrobial activities than the parental compound, which encourages us to isolate and identify filamentous fungus strains that are capable of PCA modification with unique functional features [24]. In green chemistry, filamentous fungus is considered an effective microorganism due to its excellent efficiency in conducting the biotransformation of various substrates [25]. The previous study explored the strain Aspergillus sclerotiorum CBMAI 849, which acts as a whole-cell biocatalyst and modifies the potent antioxidant 2-hydroxychalcone into hydroxydihydrochalcone [26]. In addition, 2,5-furandicarboxylic acid (FDCA) is an important bio-based source for biodegradable polyesters production and has been identified as a top future opportunity for the chemical industry by the U.S. Department of Energy (US DOE) [27]. Thus, the precursor metabolite 5-hydroxymethyl furfural (HMF) is oxidized by filamentous fungus strains A. flavus and A. niger (NRRL 567) and produces 2,5-furandicarboxylic acid (FDCA) [28]. According to the best of our knowledge, there has not been any report regarding the whole-cell biocatalysis of PCA by filamentous fungus Aspergillus sclerotiorum. The present study aims to explore the potential of Aspergillus sclerotiorum as a biotransformation agent for the production of 3-hydroxy phenazine 1-carboxylic acid (3-OH-PCA) through the whole-cell biotransformation of PCA. The fungus strain was initially identified from red spots that appeared as a contaminant in the cultured plate of the PCA-producing bacterial strain P. chlororaphis GP72. The study subsequently screened favorable carbon sources for the production of Aspergillus sclerotiorum pellets and optimized the physicochemical parameters to design an efficient whole-cell biocatalysis system for the production of 3-OH-PCA. Furthermore, the biocatalytic potential of the fungal pellets was explored in cycling mode in the fed-batch fermentation. These findings contribute to the knowledge that the strain Aspergillus sclerotiorum displays the potential to become a significant biotransformation agent. In the future, this research could lead to the development of more efficient and sustainable biotransformation processes that utilize fungal strains for the production of valuable metabolites.
2. Materials and Methods
2.1. Selection of Chemicals and Media
The principal organisms studied, Aspergillus sclerotiorum, were isolated as contaminants and identified in our laboratory. A stock culture of a newly isolated fungus strain (Aspergillus sclerotiorum) was maintained on a yeast peptone dextrose (YPD) medium. The YPD medium contained (g L−1): glucose 30.0, peptone 10.0, and yeast extract 5.0 [29]. Phenazine-1-carboxylic acid (purity ≥ 98%) was purchased from Nonglebio Co., Ltd., Shanghai, China. The composition of mineral salts medium (MSM) was modified and contained NH4Cl 2.0 g/L, K2HPO4 5.2 g/L, KH2PO4 3.7 g/L, Na2SO4 1.0 g/L, and MgSO4 0.1 g/L as previously reported [30]. However, the composition of trace elements solution was composed of 35 mg/L CuSO4. 5H2O, 50 mg/L H3BO3, 40 mg/L MnSO4. 7H2O, 40 mg/L ZnSO4. 7H2O, 20 mg/L CO(NO3)2. 6H2O, 30 mg/L (NH4)6Mo7O24. 4H2O mg/L. The Czapek mineral salt medium with the following composition (g L−1) was used to isolate fungal strain: MgSO4.7H2O 0.5, K2HPO4 0.5, NaNO3 2.0, KCl 0.5, FeSO4.7H2O 0.01, KH2PO4 0.5, and 30 g glucose. The solid medium was made by mixing 12 g/L agar with the proper liquid media. The initial pH of the medium was maintained at 7.0 and sterilized for 15 min at 121 °C. YPD medium was supplemented with various carbon sources such as glucose, glycerol, and xylose to screen the most suitable carbon source for obtaining a whole-cell biomass mass of A. sclerotiorum. All of the chemicals used in this experiment were of analytical grade.
2.2. Isolation and Identification of Fungus Strain
Czapek mineral salt medium and the broad-spectrum antibiotics gentamycin (50 mg/mL) were employed and the fungus strain was isolated from the red spot of contaminated Petri dishes of P. chlororaphis GP72. The fungus strain was repeatedly subcultured on Czapek agar medium plates to ensure pure culture and obtained conidiospores. To further view the colony morphology and texture, fungi were inoculated on modified Czapek Yeast Agar (CYA) plates and grown at 28 °C for 14 days as previously reported [31]. The genomic DNA (Aspergillus sclerotiorum) was extracted using a Takara (Takara BioInc., Shiga, Japan) genomic DNA extraction kit. The internal transcribed spacer (ITS) region was selected for fungal strain identification due to its small size and practicality, and mycologists endorsed it as the official barcode for fungal identification [32]. The PCR for the entire internal transcribed spacer (ITS) region (ITS1, 5.8S, ITS2) amplification was carried out using the universal oligonucleotide primers (IT1F—CTTGGTCATTTAGAGGAAGTAA and ITS4—TCCTCCGCTTATTGATATGC). The thermocycling parameters utilized for the amplification were typically 95 °C for 5 min of denaturation, 35 cycles at 94 °C for 30 s of annealing, 52 °C for 30 s of annealing, and 72 °C for 8 min of extension, as described in previous studies [33]. Following that, the PCR results were run on an ethidium bromide-stained 1% agarose gel with a 1kb DNA ladder to determine the most probable size of the amplified DNA fragment (550 to 650 bp). The amplified products were purified using a PCR purification kit (Takara Bio, Dalian, China). DNA fragments were subsequently sequenced by Sunny Biotech Co., Ltd. (Shanghai, China). The Basic Local Alignment Search Tool program in the National Center for Biotechnology (NCBI) was used and performed sequence alignment. To determine the evolutionary homology of a fungus with other organisms, a bootstrap consensus phylogenetic tree was constructed by comparing multiple sequences of 14 strains using the neighbor-joining (NJ) method and the molecular evolutionary genetics analysis tool MEGA-X [34].
2.3. Whole-Cell Biotransformation of PCA by Aspergillus sclerotiorum
A two-stage culture model was utilized for the whole-cell biocatalysis of PCA. In the first stage, fungal spores were inoculated into a 250 mL Erlenmeyer flask containing 50 mL YPD medium at a concentration of 1 × 109 mL−1 and shaken at 200 rpm under 28 °C for 60 h. Hence, several distinct well-defined morphological pellets formed in the flasks. For the biotransformation reaction, 60-h old pellets of A. sclerotiorum were collected and washed three times with PBS solution. Thus, in the second stage, the fungus pellets of each pre-cultured flask were re-suspended into a 250 mL Erlenmeyer flask containing 50 mL of MSM medium with 336 mg/L of PCA (Nongle Co., Ltd., Shanghai, China). The Erlenmeyer flask culture was incubated for 36 h at 28 °C, 200 rpm. Each sample was collected in triplicate at every 6-h interval and further evaluated for PCA biotransformation. Moreover, fungal pellets were harvested and washed by vacuum filtration with 66.7% Acetic Acid solution with various pH 3.0, pH 4.0, pH 5.0, pH 6.0, and pH 7.0, and released the adsorbed compound that was analyzed as previously reported [35].
2.4. Isolation and Extraction of the Target Compound
The biotransformation broth containing whole cell biomass was collected and acidified with acetic acid with pH 2.0 and extracted with ethyl acetate by vigorous shaking before being static for phase separation. The extraction was collected, evaporated, and concentrated under reduced pressure at 33 °C. The obtained crude extracts were loaded on a lab-scale glass chromatographic column (4 cm × 45 cm) containing Macroporous resin Diaion HP-20 (M-Chemical Co., Ltd., Tokyo, Japan). Furthermore, we eluted the column with different ratios of methanol solutions (100%-water, 20% methanol, 50% methanol, 100% methanol) and optimized the condition of 3-OH-PCA purification following the procedure previously described [8]. The collected samples were further analyzed through HPLC (Agilent series 1200 system, Agilent Technologies Group, Santa Clara, CA, USA) equipped with a C-18 reversed-phase column (4.6 × 250 mm, 5 mm; Agilent Technologies) and a UV detector (Agilent, Santa Clara, CA, USA) to disclose the best pioneer solution for 3-OH-PCA separation and purification. Moreover, UPLC-MS analysis was carried out on UPLC Acquity/Q-TOF MS Premier (Waters Co., Ltd., Milford, DE, USA) for the structure elucidation of the target compound.
2.5. The Effect of Various Factors on the Whole-Cell Biotransformation of PCA
Unless specified, the MSM medium with a pH value of 6.0, a PCA concentration of 336 mg/L, 200 rpm, and a dry cell weight of 10 g/L was incubated at 28 °C. First, the fungus pellets were added to MSM medium and samples were collected at a specific interval to assess the biotransformation performance by measuring the concentration of PCA and its derivative 3-OH-PCA. Various factors, such as PCA concentration, pH, temperature, rotatory rates, and different fungus biomass concentrations were investigated in order to optimize conditions for enhancing the PCA biotransformation capabilities of A. sclerotiorum. Subsequently, to determine the effect of various factors on the biotransformation performance, single-factor tests were set with 50 mL of the reaction mixture in 250 mL Erlenmeyer flasks and adopted the pattern as previously reported [36]. (1) PCA concentrations 4 mM (896 mg/L), 5 mM (1120 mg/L), 6 mM (1344 mg/L), 7 mM (1568 mg/L), and 8 mM (1792 mg/L; (2) pH levels: 3.0, 5.0, 7.0, and 12.0; (3) temperatures: 25, 30, 33, 37, and 42 °C; (4) rotatory rates: 0, 50, 100, and 200 rpm; (5) fungus biomass (DCW): 20, 15, 10, and 5 g/L. Samples were drawn every 12 h and the total incubation time was 96 h. The same optimized conditions were used for subsequent experiments.
2.6. Time Course of Whole-Cell Biotransformation of PCA and the Production of 3-OH-PCA
The whole-cell biocatalysis reaction was assessed under the optimal conditions of 15 g/L of DCW, 1120 mg/L of PCA, and pH 7.0. The flasks containing 50 mL of the reaction mixtures were incubated in the shaker at 200 rpm and 25 °C. Hence, the samples were collected at 12-h intervals. After 60 h of incubation, the reaction was stopped by adding 66.7% acetic acid and extracted using ethyl acetate [35]. After vigorous shaking and centrifugation for 5 min, the organic phase was separated, evaporated, and re-suspended in acetonitrile for HPLC analysis.
2.7. The Reusability of Fungus Pellets for Fed-Batch Fermentation
The biotransformation efficiency of A. sclerotiorum pellets was separately investigated in the repeated-batch mood with glucose supplement and without glucose supplement, where the MSM medium with optimized PCA concentration (1120 mg/L) was replenished at the end of each cycle and the fungus pellets were accordingly recycled [37]. In addition, the glucose supplement (20 g/L) was provided at the end of each cycle in parallel with the no glucose supplement group to uncover the sustainability of biotransformation potential of fungal pellets in parallel conditions. The steps for the reutilization of fungus pellets were repeated five times with each resident time at 60 h. After 60 h of incubation, the fungus pellets were harvested, centrifuged, cleaned, and inoculated in the new flask of MSM media with the same concentration of PCA (1120 mg/L) for the next cycle of biocatalysis.
2.8. Analytical Methods for PCA Biotransformation
In order to measure the concentration of newly produced PCA deravatives, 1 mL of fermentation broth was collected, centrifuged, adjusted to pH 2.0, and then 2 mL of ethyl acetate was added and vigorously shaken for 5 min before being static for phase separation. The organic layer was collected, vacuum dried, re-suspended in 1.0 mL of acetonitrile, and filtered through a 0.22 μm filter for HPLC. The mobile phase composed of acetonitrile and 0.1% formic acid had a gradient profile as follows: 0–5 min, 20% acetonitrile; 5.01–15 min, 40% acetonitrile; and 15–20 min, 20% acetonitrile. The wave length used for the detection of the newly accumulated compound was 254 nm with a 1 mL/min flow rate by infusing a 20-µL sample via an auto-sampler eluted under isocratic conditions. Fungus biomass was separated and dried at 50 °C. Then, the dried cell weight was calculated as previously reported [38]. All obtained values are the means of three replicates as a standard deviation. Moreover, ultra-performance liquid chromatography and mass spectrometry (UPLC-MS) was carried out using UPLC Acquity/Q-TOF MS Premier (Waters Co., Ltd., Milford, CN, USA). The mass spectrometer was run in positive ion detection mode set to scan between 50 and 1000 m/z.
2.9. Statistical Analysis
The experiments performed in this study were run in triplicate, and data were recorded as mean values ± standard deviation (SD) and statistical analysis was performed using SPSS (Inc., Chicago, IL, USA).
3. Results and Discussion
3.1. Fungus Isolate Is Responsible for Red Pigment Production
Pseudomonas chlororaphis had previously been investigated in our laboratory for the synthesis of different phenazine derivatives, such as PCA, 2-hydroxyphenazine (2-OH-PHZ), and 2-hydroxyphenazine 1-carboxylic acid (2-OH-PCA) [39,40]. In many instances, spontaneous strikingly red pigments have been observed as a contaminant in the LB cultured plate of P. chlororaphis GP72 incubated at 28 °C, as shown in Figure 1A. Thus, in the current study, the fungus strain was screened from the red spots of the contaminated plate of P. chlororaphis GP72 and repeatedly sub-cultured on Czapek mineral salt medium with broad-spectrum antibiotic gentamycin (50 mg/mL), but no red spots were observed, as illustrated in Figure 1B. We detected the recurrence of the red color pigments by re-inoculating the fungal strain into plates containing P. chlororaphis GP72 and validated it by repeating the experiment multiple times, as portrayed in Figure 1C. In addition, a white colony of pure fungus culture was obtained on CYA media, as shown in Figure 1D. The red pigments were thoroughly studied, revealing that they were caused by fungal strain and modifying the structure of pre-existing PCA into another derivative in the culture plate.
Figure 1.
The fungus strain was screened and the pure culture was obtained. (A) Old contaminated LB plate of P. chlororaphis GP72 showing red spots. (B) Isolated fungal strain devoid of red spots on Czapek agar medium. (C) The fungus plate was re-inoculated with P. chlororaphis GP72 and a red color appeared. (D) Colony of the pure fungus culture on CYA medium. The red arrows represent the direction of steps followed for the screening of fungus strain.
3.2. Identification of Fungus Strain as Aspergillus sclerotiorum
In order to explore the identity of the fungus strain responsible for the production of red pigments in the culture plate of P. chlororaphis GP72, the fungus ITS sequence was determined and based on the blast analysis by using validated reference sequences (National Center for Biotechnology Information); the sequence of the entire internal transcribed spacer (ITS) (ITS1, 5.8S, ITS2) exhibited the greatest identity with the genus Aspergillus (gene bank accession no., MW386817.1). When the sequence identity of the fungal internal transcribed spacer (ITS) region (ITS1, 5.8S, ITS2) was compared to pre-existing sequences in the Gene Bank database, the newly isolated strain was classified as Aspergillus sclerotiorum. Additionally, our claim was supported by an evolutionary framework in the phylogenetic tree (Figure 2A). Multiple sequence alignment of the ITS sequence (ITS1, 5.8S, ITS2) of 14 strains using the neighbor-joining (NJ) method with the molecular evolutionary genetics analysis tool MEGA-X resulted in a bootstrap consensus phylogenetic tree. Hence, the results of ITS sequence comparison suggested that the newly isolated fungus strain exhibited 100% homology with Aspergillus sclerotiorum. Macroscopical study of Aspergillus sclerotiorum onto Czapek yeast agar (CYA) medium showed white mycelia and liquid colony exudate, while the spore was beige in color (Figure 2B), as previously reported [41]. Thus, the fungal strain A. sclerotiorum was validated following extensive analysis using morphology and culture characterization, coupled with molecular identification.
Figure 2.
(A) Phylogenetic tree of Aspergillus sclerotiorum (MW386817) and related species. Based on the ITS sequence analysis, the newly isolated strain in this study relies on the same clades as Aspergillus sclerotiorum, portrayed in the evolutionary tree with red box. (B) The fungus strain on Czapek yeast agar (CYA) medium showed white mycelia and had liquid colony exudate, but the spore was beige in color.
3.3. Whole-Cell Biocatalysis of Phenazine 1-Carboxylic Acid by Aspergillus sclerotiorum
Currently, various genera of microorganisms capable of biotransformation of PCA have been reported, such as Nocardia, Mycobacterium, Sphingomonas, and Streptomyces [18,19,20,21,29]. In addition to bacteria, some studies have demonstrated PCA modification by growing cells of filamentous fungi [22,23]. However, the strain Aspergillus sclerotiorum has never been reported to carry out whole-cell biocatalysis of PCA. Hence, the current work explored PCA modification by filamentous fungal strain A. sclerotiorum and portrayed outstanding efficiency in biotransformation via whole-cell biocatalysis processes. In order to explore the biocatalytic potential of Aspergillus sclerotiorum, the biomass was obtained from YPD medium and incubated in MSM containing 336 mg/L of PCA for 36 h. As shown in Figure 3A, there was a time-varying reduction in PCA during the incubation, while the control group still remained at the original concentration; the results were significant (p < 0.05). To further determine the direction of PCA flux, we searched the HPLC profiles of PCA-feeding experimental samples (Figure 3B). A new peak (retention time: 11 min) with a time-varying increase in peak area was detected, which confirmed that Aspergillus sclerotiorum strain is able to transform PCA into new compound, and later confirmed 3-OH-PCA. As the results show, there was a complete depletion of PCA (336 mg/L) after 30 h and an accumulation of 280 mg/L (Figure 3C).
Figure 3.
(A) Biotransformation of PCA by A. sclerotiorum (treated group and control group). (B) HPLC chromatogram of new compound (3-OH-PCA) and substrate PCA, peaks at 11.2 and 14 min, respectively. (C) Concentration of the newly accumulated compound (3-OH-PCA). Data are represented as mean ± SD in replicates (n = 3).
We further determined that the pH of the culture broth rises from 6.0 to 7.0 during 30 h of incubation, which may affect the solubility and distribution of newly accumulated compounds, as shown in Figure 4A. Hence, the newly formed compound is sensitive and changes color with a change in pH, which may affect its distribution, as shown in Figure 4D. In addition, the fungus pellets provided enough surface area for extracellular metabolites to be adsorbed. Thus, we collected the fungus pellet and washed it with vacuumed filtration using different concentrations of acetic acid solution (pH 3.0, pH 4.0, pH 5.0, pH 6.0, and pH 7.0) and released the trapped compound. As shown in Figure 4B, the solution with pH 3.0 showed a comparatively good effect (20 mg/L) than pH 4.0 and 5.0, while the removal effect of the neutral solution with pH 6.0 and 7.0 did not show a good effect. In brief, a relatively strong acidic solution was better than a weak one in terms of its effect on 3-OH-PCA removal, and the results were significant (p < 0.01). Therefore, the total concentration of 3-OH-PCA reached up to 300 mg/L, in which 6% was located on the pellet, while 94% was accumulated in the filtrate, as illustrated in Figure 4C.
Figure 4.
(A) Time courses of broth pH. (B) Effect of various washing solutions on the removal of 3-OH-PCA from the fungal pellets. (C) Distribution of the newly produced compound (3-OH-PCA) in the cultured of Aspergillus sclerotiorum in a shake flask. (D) The newly formed compound is sensitive and changes color with pH change. Data are represented as mean ±SD in replicates (n = 3). Note: * p < 0.05, ** p < 0.01, N/S: Not significant.
3.4. Purification and Structure Elucidation of the Biotransformation Product
After the confirmation that a new product was accumulated through the whole-cell biocatalysis of PCA, a large-scale (4L) biotransformation experiment was conducted and the accumulated product was purified through ethyl acetate extraction and silica gel column chromatography, as shown in Figure 5A. After the purification process, a total of 1 g of new metabolite (3-OH-PCA) was obtained from 1.3 g of PCA. The high-resolution mass was determined by UPLC-MS analysis, as shown in Figure 5B. The high-resolution mass of the new compound from the [M + H]+ peak was m/z 241.0539 (calculated for C13H8N2O3, 241.0539), suggesting that the molecular formula was C13H8N2O3, as previously reported [22].
Figure 5.
(A) Flow chart of the extractions and purification of phenazine metabolite 3-OH-PCA. (B) UPLC-MS spectrum of the newly accumulated compound. The molecular mass of the new compound was calculated to be 241.0539 (m/z 241.0539).
3.5. Whole Cell Biomass Preparation of A. sclerotiorum from Glucose
As 3-OH-PCA showed a strikingly condensed red color and possibly acted as a coloring agent, there is a need to search for a low-cost method for the production of fungus pellets. Thus, a proficient whole-cell biotransformation system was developed, with the production of PCA 10 g/L as previously reported [42]. Rich medium is the best option to prepare the whole-cell biomass of fungal strain A. sclerotiorum; subsequently, we used YPD medium following biotransformation reaction in mineral salt medium. Firstly, the growth of fungus strain A. sclerotiorum was investigated in YPD medium containing 20 g/L different carbon sources, including glycerol, glucose, and xylose. As illustrated in Figure 6A, the strain A. sclerotiorum can grow in YPD medium with the abovementioned carbon sources. The dry cell weight (DCW) reached up to 10.6 g/L after the strain was incubated for 60 h in YPD medium containing glucose and glycerol as a carbon sources, which was higher than that obtained in YPD medium containing xylose; the results were significant (p < 0.01). In the first 36 h and 48 h, the growth efficiency of the fungal strain was higher on the medium containing glycerol as a carbon source, while after 60 h of incubation, the dry cell weight of the fungal strain obtained from the medium containing glucose was similar to glycerol. Glucose is a major carbon source in microbial fermentation and is widely produced through the natural process of photosynthesis. Thus, the strain A. sclerotiorum was further cultivated by using different concentrations of glucose as a carbon source in YPD medium. As shown in Figure 6B, the dry cell weight of the fungal strain initially increased with the added glucose concentration and reached up to 10 g/L, but further enhancement in the dry cell weight of the fungal biomass was negligible when the concentration of glucose was higher than 20 g/L. Thus, the YPD medium containing 20 g/L was selected to prepare fungal biomass for the whole-cell biocatalysis of PCA.
Figure 6.
Screening carbon sources for the preparation of A. sclerotiorum whole cells. (A) Dry cell weight (DCW) of A. sclerotiorum cultivated in (YPD) medium supplemented with different carbon sources. (B) The DCW and biomass production using different concentrations of glucose. Data are represented as mean ± SD in replicates (n = 3). Data are represented as mean ± SD in replicates (n = 3). Note: * p < 0.05, ** p < 0.01, *** p < 0.001, N/S: Not significant.
3.6. Biocatalytic Production of 3-OH-PCA under Optimized Conditions
The biocatalytic production of a new metabolite from PCA catalyzed by A. sclerotiorum was assessed for critical optimization factors, such as substrate concentration, rotatory rate, pH, and temperature. In terms of enzyme overproduction, altering the culture conditions could be more helpful than genetic alteration [43,44]. Therefore, culture conditions were optimized in the current study using a one-variable-at-a-time procedure.
3.7. The Effect of PCA Concentration on the Biocatalytic Production of 3-OH-PCA
The substrate concentration is an essential variable in biocatalysis reactions, and it requires thorough research to reveal the toxicity of the substrate. Different PCA concentrations of 4 mM (896 mg/L), 5 mM (1120 mg/L), 6 mM (1344 mg/L), 7 mM (1568 mg/L), and 8 mM (1792 mg/L) were tested to determine its effect on A. sclerotiorum biotransformation efficiency. As demonstrated in Figure 7A,B, the strain A. sclerotiorum could completely biotransform PCA into a new metabolite (3-OH-PCA) within 60 and 72 h, as PCA concentrations were 896 and 1120 mg/L, respectively. The maximum accumulated concentrations of the newly formed compound (3-OH-PCA) were 850 and 1030 mg/L, respectively. The production rates of the newly formed compound were 14.16 and 15.5 mg/L/h as the initial concentrations of PCA were 896 and 1120 mg/L, respectively. PCA could not be entirely biotransformed as the initial PCA concentration was higher than 1344 mg/L. The conversion efficiency of PCA was 94.8% and 92% and resulted in 850 and 1030 mg/L of the newly formed compound. Therefore, according to the obtained results, the bioconversion rate of PCA and the net accumulation of 3-OH-PCA were higher when the concentration of PCA was 1120 mg/L, and the results were significant (p < 0.01). Thus, we used this concentration for the following experiments.
Figure 7.
Biotransformation of various PCA concentrations into 3-OH-PCA using strain A. sclerotiorum. (A) Concentration of PCA, (B) production of 3-OH-PCA. Data are represented as mean ± SD in replicates (n = 3).
Consistent with our study, substrate concentration positively influences the bioconversion process of 2-methyl-1-phenyl propane-1-one up to 33.7 Mm (5.0 g), but has an inhibitory impact as its concentration increases. This suggests that the enzyme activity decreases with increasing concentration, resulting in substrate toxicity [45,46]. Another study emphasized the relevance of the substrate concentration in the whole-cell biocatalysis process, and comparable characteristics were observed in whole cells of the fungus Aspergillus flavus. When the substrate soybean saponin concentration was increased from 2%, the biotransformation rate was reduced along with an inhibition of Soyasapogenol B synthesis [45]. Several studies have revealed the same phenomenon during chiral chemicals production in the whole-cell biocatalysis reaction of recombinant strain E. coli [47]. Similarly, the biocatalytic potential of fungal strain Aspergillus sydowii CBMAI 934 reduced with increasing phenyl acetonitrile concentration from 20.0 µL, with no substrate conversion into the corresponding carboxylic acid at 40.0 and 60.0 µL nitrile [48]. Therefore, the results of the current study determined that the substrate concentration is critical in precisely determining the capacity of the whole-cell biocatalysis process.
3.8. Effect of Initial pH on the Biotransformation of PCA
The pH had a significant impact on the overall efficiency of the biocatalysis process in the cell. In the current study, the biotransformation of PCA was performed at various pH values (3.0, 5.0, 7.0, 9.0, and 12.0) using strain A. sclerotiorum. When the initial pH values were 5.0 and 7.0, strain A. sclerotiorum could completely biotransform PCA within 72 h, respectively. Hence, comparing the biocatalytic potential of the strain A. sclerotiorum between pH 5.0 and 7.0, the biotransformation rate of PCA was the highest at pH 7.0 between 24 h and 60 h. As a result, 3-OHP-PCA was significantly accumulated and its concentrations were 1045 and 990 mg/L, respectively. Although, the PCA biotransformation at pH 9.0 was not good and the residual PCA concentration was stable up to the end of fermentation, as shown in Figure 8A,B. The PCA biotransformation efficiency was 62.5% and 700 mg/L 3-OH-PCA was obtained at the initial pH value of 9.0; the results are significant (p < 0.001). According to the obtained results, the PCA was well biotransformed under neutral conditions. The ionic state of enzymes, substrates, and products modified by pH can directly or indirectly affect enzyme activity and significantly impact substrate-enzyme active site interaction [49]. Furthermore, the substrate’s solubility and ionic state, which fluctuate with pH, influence the enzyme’s selectivity and active site [50,51]. Consequently, pH altered the enzyme’s structure and active site, resulting in a distinct interaction of the active site with the substrate, which impacted the rate of biocatalysis in A. sclerotiorum. Hence, a neutral pH of 7.0 was employed for the biocatalytic production of 3-OH-PCA.
Figure 8.
Biotransformation of PCA into 3-OH-PCA at various initial pHs using strain A. sclerotiorum in shaking flasks. (A) PCA (B) 3-OH-PCA. Data are represented as mean ± SD in replicates (n = 3).
3.9. Effect of Incubation Temperature on the Biotransformation of PCA
The temperature has a significant impact on the biocatalyst’s stability, activity, and selectivity. Therefore, we evaluated the effect of various temperatures (25 °C, 30 °C, 33 °C, 37 °C, and 42 °C) on the PCA biocatalytic process. Strain A. sclerotiorum could completely biotransform 1120 mg/L within 72 h under 25–30 °C. Comparing the whole-cell biocatalysis of PCA within 36 h and 60 h, the PCA biotransformation rate at 25 °C was the highest, followed by 30 °C. The accumulated 3-OH-PCA concentrations were 1040 and 1005 mg/L, respectively. However, the PCA biotransformation rates at 33 °C and 37 °C within the first 24 h were the highest among the various incubation temperatures, and the biocatalysis declined significantly after 24 h. At least 84 h and 96 h are needed to biotransform PCA, and the concentration of accumulated 3-OH-PCA was 920 and 910 mg/L, respectively, as shown in Figure 9A,B. However, at 42 °C, the enzymes were completely inhibited, and no biocatalytic activity was detected with any significant difference (p < 0.001). Thus, the current study advocated the role of an optimal temperature (25 °C) in the effective whole-cell biotransformation of PCA.
Figure 9.
Biotransformation of PCA into 3-OH-PCA at various temperatures using strain A. sclerotiorum. (A) PCA (B) 3-OH-PCA. Data are represented as mean ± SD in replicates (n = 3).
3.10. Effect of Agitation Rate(rpm) on the Biotransformation of PCA
The effect of the agitation speed on the transfer rate of substrate particles in the biocatalysis process plays a crucial role in its efficiency. Therefore, in the current study, the rotation rate (RPM) optimization for PCA biotransformation was performed at various rotatory rates (200, 100, 50, 0) using strain A. sclerotiorum. When the agitation value was 200 rpm, the capability of PCA biotransformation was optimal and 1120 mg/L of PCA was depleted within 72 h of incubation. As a result, 1050 mg/L of 3-OH-PCA was accumulated during the same incubation period. Moreover, the PCA biotransformation potential of the fungal strain was comparatively reduced during the agitation of 100 rpm, and PCA residues were sustained until the end of the experiment. The conversion efficiency of PCA was 83% and 970 mg/L 3-OH-PCA was obtained. However, the bioconversion efficiency of PCA was not good during the agitation rate of 50 rpm and residual PCA was sustained; hence, the accumulated concentration of 3-OH-PCA was 820 mg/L, as shown in Figure 10A,B. Apart from that, the biotransformation efficiency of PCA at 0 rpm was 19.6% with a significant difference (p < 0.001) and the concentration of accumulated 3-OH-PCA 220 mg/L. Briefly, the highest biocatalytic conversion of PCA was found at 200 rpm, attributable to the fact that a high rotatory rate could have altered the internal structure of the cells by increasing stress distribution on the strain A. sclerotiorum [52].
Figure 10.
Biotransformation of PCA at various rotation rates ranging from 0 rpm to 200 using strain A. sclerotiorum. (A) PCA, (B) 3-OH-PCA. Data are represented as mean ± SD in replicates (n = 3).
3.11. Fungus Biomass Optimization and Its Effect on the Longevity on the Biotransformation of PCA
It is apparent that the biomass concentration will affect the longevity of the whole-cell biocatalysis of PCA; thus, four different concentrations of whole-cell biomass (5, 10, 15, 20 g/L DCW) were used and biotransformation was carried out. As expected, the use of a biocatalyst in higher concentrations did not lead to better biotransformation results, but inversely affected the longevity of PCA biocatalysis. When the concentration of the dry biomass of the fungal strain was 20 g/L, the biotransformation efficiency of the PCA between 12 h and 48 h was less than 15, 10 g/L of biomass and took 72 h for the full depletion of PCA. Hence, the concentration of accumulated 3-OH-PCA was 1000 mg/L. Moreover, when the concentration of whole-cell biomass was 15 g/L, the biotransformation efficiency was the highest with the lowest longevity (60 h) of PCA biotransformation. As a result, the accumulated concentration of 3-OH-PCA was 1060 mg/L. However, when the biomass concentration was 10 g/L, the longevity of the biotransformation was 72 h, while its efficiency was good within 12 h and 48 h with 20 g/L of biomass. The accumulated concentration of 3-OH-PCA was 1015 mg/L. In the case of 5 g/L of biomass, the efficiency of biotransformation was not good with a significant difference (p < 0.05) and the PCA residues were sustained until the end of the experiment, as shown in Figure 11A,B. Briefly, various biomass concentrations of 5, 10, 15, and 20 g/L showed bioconversion efficiencies of 89.2%, 94%, 90.6%, and 62%, respectively, while the concentration of the accumulated 3-OH-PCA was 1000, 1060, 1015, and 700 mg/L.
Figure 11.
Biotransformation of PCA into 3-OH-PCA at various biomass concentrations using strain A. sclerotiorum. (A) PCA, (B) 3-OH-PCA. Data are represented as mean ± SD in replicates (n = 3).
3.12. Time Course of 3-OH-PCA Production in One-Pot Whole-Cell Biotransformation of PCA
Based on the optimized conditions mentioned above, the time course of whole-cell biocatalysis of PCA for the production of 3-OH-PCA was explored, as shown in Figure 12 Strain A. sclerotiorum smoothly modified PCA and the accumulation of 3-OH-PCA consecutively increased. After incubation for 60 h, the PCA was completely depleted for the production of 3-OH-PCA. Overall, 1060 mg/L of 3-OH-PCA was produced from 1120 mg/L of PCA in 60 h; thus, the conversion rate of PCA into 3-OH-PCA was 94% and the results were significant (p < 0.001). The Aspergillus genus has been historically used due to its immense metabolic potential to perform biotransformation. Therefore, various studies have investigated its whole-cell biotransformation potential and modified various natural products, such as steroids, flavonoids, and 2-hydroxychalcone [26,53]. It is worth noting that this is the first scientific study providing evidence of PCA whole-cell biocatalysis by the filamentous fungus strain A. sclerotiorum at an unprecedented concentration. Here, it was determined that PCA can be transformed to 3-OH-PCA with hydroxylation at the C-3 position. Various phenazines, such as PYO, HDPCA, and terpenoid phenazines, have been previously described; only the biosynthesis of PYO from PCA has been clearly identified in that NADPH-dependent flavoprotein monooxygenase PhzS triggers the hydroxylation after PhzM catalyzes the N-methylation of PCA [54]. Here, we supposed that cytochrome P450-dependent monooxygenase may be involved in the production of 3-OH-PCA, which could be identified through enzymatic verification and genome mining.
Figure 12.
Time course of biocatalytic production of 3-OH-PCA by whole-cell biotransformation of PCA. Data are represented as mean ± SD in replicates (n = 3).
3.13. Repetition and Continuous Utilization of Fungus Pellets for Fed-Batch Fermentation
Biocatalyst recycling is considered a major element in the industrial process of whole-cell biocatalysis [55]. Therefore, the biotransformation efficiency of A. sclerotiorum pellets was separately investigated in repeated-batch mood with glucose supplement and without glucose supplement where MSM medium with optimized PCA concentration (1120 mg/L) was replenished at the end of each cycle and the fungus pellet was recycled. The study was conducted over five cycles with a residence time of 60 h, as shown in Figure 13A. In all of the cycles, biotransformation occurred using the optimized conditions with a residence time of 60 h. In the first cycle, the biocatalytic production of 3-OH-PCA was 1055 mg/L, which indicated that the biotransformation efficiency of PCA was 94%. Consequently, the accumulation of 3-OH-PCA decreased with each next cycle, such as 980, 750, 500, and 300 mg/L and the PCA biotransformation efficiencies were 87%, 67%, 44%, and 26%, respectively, and the results were significant (p < 0.001). Nevertheless, the biotransformation efficiency of each group decreased with each subsequent cycle, but the fungal pellets retained their original shape and integrity. This might be ascribed to the fungal strain being regularly exposed to homologous concentrations of PCA in fresh flasks, causing unfavorable and inhibitory effects on the strain [37]. It is also conceivable that the cofactor’s regeneration capability of the pellets reduced with each cycle attributed to nutrient deficiency, resulting in a potential catalytic reduction of the enzyme. Therefore, additional carbon sources could be used to sustain the biocatalytic capability of the fungal pellets [56]. Thus, as shown in Figure 13B, a glucose supplement (20 g/L) was added at the end of each cycle and the biocatalytic efficiency of fungal pellets were resumed and sustained until the end of the fifth cycle.
Figure 13.
Biotransformation of PCA into 3-OH-PCA using pellets of Aspergillus sclerotiorum in recycling mood with a residence time of 60 h. (A) No glucose supplement addition at the end of each cycle. (B) Glucose supplement addition at the end of each cycle. Data are represented as mean ± SD in replicates (n = 3). Data are represented as mean ± SD in replicates (n = 3). Note: * p < 0.05, ** p < 0.01, *** p < 0.001, N/S: Not significant.
4. Conclusions
In this study, the fungus strain was isolated from the contaminated culture plate of PCA-producing bacterial strain Pseudomonas chlororaphis GP72. The strain was identified as Aspergillus sclerotiorum and was found to exhibit proficient PCA modification capabilities resulting in the production of 3-OH-PCA. A gram-scale (4L) biotransformation reaction was performed and utilized 1.3 g of PCA, resulting in the production of 1 g of a compound confirmed as 3-OH-PCA through UPLC-MS analysis, exhibiting a high-resolution mass of m/z 241.0539. Finally, a more proficient whole-cell biocatalytic system was designed for the production of 3-OH-PCA by screening different carbon sources and optimizing physiochemical parameters. In recycled batch fermentation, the biotransformation efficiency of fungal pellets decreased with each cycle; hence, adding glucose as a carbon source restored the biocatalytic potential, ensuring sustainable efficiency. The derivative metabolite 3-OH-PCA has a red condensed color and might have some potential as a dye in biochemical and biological industries, but further explorations are necessary. Furthermore, these findings will serve as the basis for future studies and using this strain for the industrial-scale biocatalytic synthesis of 3-OH-PCA. The mechanism and appropriate pathway of PCA biotransformation by strain A. sclerotiorum are still underway. Additional research is needed to explore its commercial applicability.
Author Contributions
Conceptualization, M.J. and H.-B.H.; methodology, M.J.; validation; formal analysis, M.J. and S.-J.Y.; investigation, M.J.; data curation, M.J.; writing—original draft preparation, M.J.; writing—review and editing, R.-X.D., S.-J.Y., Y.-F.N., H.-Y.Z., X.-R.H. and W.W.; project administration, H.-B.H. and X.-H.Z.; funding acquisition, X.-H.Z. All authors have read and agreed to the published version of the manuscript.
Funding
National Key R&D Program of China (Grant no. 2019YFA0904300) and National Natural Science Foundation of China (Grant no. 21878184 and 32070051).
Institutional Review Board Statement
Not applicable.
Informed Consent Statement
Not applicable.
Data Availability Statement
Not applicable.
Acknowledgments
The authors are grateful to the Instrumental Analysis Center of Shanghai Jiao Tong University for their expert technical assistance in HPLC and UPLC-MS.
Conflicts of Interest
The authors declare no conflict of interest.
References
- Alvarez-Fitz, P.; Alvarez, L.; Marquina, S.; Luna-Herrera, J.; Navarro-García, V.M. Enzymatic reduction of 9-methoxytariacuripyrone by Saccharomyces cerevisiae and its antimycobacterial activity. Molecules 2012, 17, 8464–8470. [Google Scholar] [CrossRef] [PubMed]
- Feng, J.; Wu, Q.; Zhu, D.; Ma, Y. Biotransformation Enables Innovations Toward Green Synthesis of Steroidal Pharmaceuticals. ChemSusChem 2022, 15, e202102399. [Google Scholar] [CrossRef]
- Liu, J.-H.; Yu, B.-Y. Biotransformation of bioactive natural products for pharmaceutical lead compounds. Curr. Org. Chem. 2010, 14, 1400–1406. [Google Scholar] [CrossRef]
- Alcántara, A. Biotransformations in drug synthesis: A green and powerful tool for medicinal chemistry. J. Med. Chem. Drug Des. 2018, 1, 1–7. [Google Scholar]
- Shah, S.A.; Tan, H.L.; Sultan, S.; Faridz, M.A.; Shah, M.A.; Nurfazilah, S.; Hussain, M. Microbial-catalyzed biotransformation of multifunctional triterpenoids derived from phytonutrients. Int. J. Mol. Sci. 2014, 15, 12027–12060. [Google Scholar] [CrossRef]
- Clouthier, C.M.; Pelletier, J.N. Expanding the organic toolbox: A guide to integrating biocatalysis in synthesis. Chem. Soc. Rev. 2012, 41, 1585–1605. [Google Scholar] [CrossRef]
- de Carvalho, C.C. Whole cell biocatalysts: Essential workers from nature to the industry. Microb. Biotechnol. 2017, 10, 250–263. [Google Scholar] [CrossRef]
- Bilal, M.; Yue, S.J.; Hu, H.B.; Wang, W.; Zhang, X.H. Adsorption/desorption characteristics, separation and purification of phenazine-1-carboxylic acid from fermentation extract by macroporous adsorbing resins. J. Chem. Technol. Biotechnol. 2018, 93, 3176–3184. [Google Scholar] [CrossRef]
- Lee, W.-H.; Kim, M.-D.; Jin, Y.-S.; Seo, J.-H. Engineering of NADPH regenerators in Escherichia coli for enhanced biotransformation. Appl. Microbiol. Biotechnol. 2013, 97, 2761–2772. [Google Scholar] [CrossRef] [PubMed]
- Verho, R.; Londesborough, J.; Penttila, M.; Richard, P. Engineering redox cofactor regeneration for improved pentose fermentation in Saccharomyces cerevisiae. Appl. Environ. Microbiol. 2003, 69, 5892–5897. [Google Scholar] [CrossRef]
- Pfruender, H.; Amidjojo, M.; Kragl, U.; Weuster-Botz, D. Efficient whole-cell biotransformation in a biphasic ionic liquid/water system. Angew. Chem. Int. Ed. 2004, 43, 4529–4531. [Google Scholar] [CrossRef] [PubMed]
- Piel, J. Approaches to capturing and designing biologically active small molecules produced by uncultured microbes. Annu. Rev. Microbiol. 2011, 65, 431–453. [Google Scholar] [CrossRef] [PubMed]
- Otten, S.L.; Rosazza, J.P. Microbial transformations of natural antitumor agents. 17. Conversions of lapachol by Cunninghamella echinulata. J. Nat. Prod. 1981, 44, 562–568. [Google Scholar] [CrossRef]
- Huang, Z.; Bonsall, R.F.; Mavrodi, D.V.; Weller, D.M.; Thomashow, L.S. Transformation of Pseudomonas fluorescens with genes for biosynthesis of phenazine-1-carboxylic acid improves biocontrol of rhizoctonia root rot and in situ antibiotic production. FEMS Microbiol. Ecol. 2004, 49, 243–251. [Google Scholar] [CrossRef]
- Yang, M.M.; Mavrodi, D.V.; Mavrodi, O.V.; Bonsall, R.F.; Parejko, J.A.; Paulitz, T.C.; Thomashow, L.S.; Yang, H.T.; Weller, D.M.; Guo, J.H. Biological control of take-all by fluorescent Pseudomonas spp. from Chinese wheat fields. Phytopathology 2011, 101, 1481–1491. [Google Scholar] [CrossRef]
- Mavrodi, D.V.; Mavrodi, O.V.; Parejko, J.A.; Bonsall, R.F.; Kwak, Y.-S.; Paulitz, T.C.; Thomashow, L.S.; Weller, D.M. Accumulation of the antibiotic phenazine-1-carboxylic acid in the rhizosphere of dryland cereals. Appl. Environ. Microbiol. 2012, 78, 804–812. [Google Scholar] [CrossRef] [PubMed]
- Price-Whelan, A.; Dietrich, L.E.; Newman, D.K. Rethinking’secondary’metabolism: Physiological roles for phenazine antibiotics. Nat. Chem. Biol. 2006, 2, 71–78. [Google Scholar] [CrossRef] [PubMed]
- Yang, Z.-J.; Wang, W.; Jin, Y.; Hu, H.-B.; Zhang, X.-H.; Xu, Y.-Q. Isolation, identification, and degradation characteristics of phenazine-1-carboxylic acid–degrading strain Sphingomonas sp. DP58. Curr. Microbiol. 2007, 55, 284–287. [Google Scholar] [CrossRef] [PubMed]
- Zhao, Q.; Hu, H.-B.; Wang, W.; Huang, X.-Q.; Zhang, X.-H. Novel three-component phenazine-1-carboxylic acid 1, 2-dioxygenase in Sphingomonas wittichii DP58. Appl. Environ. Microbiol. 2017, 83, e00133-17. [Google Scholar] [CrossRef]
- Costa, K.C.; Moskatel, L.S.; Meirelles, L.A.; Newman, D.K. PhdA catalyzes the first step of phenazine-1-carboxylic acid degradation in Mycobacterium fortuitum. J. Bacteriol. 2018, 200, e00763-17. [Google Scholar] [CrossRef]
- Costa, K.C.; Bergkessel, M.; Saunders, S.; Korlach, J.; Newman, D.K. Enzymatic degradation of phenazines can generate energy and protect sensitive organisms from toxicity. MBio 2015, 6, e01520-15. [Google Scholar] [CrossRef]
- Hill, J.C.; Johnson, G.T. Microbial transformation of phenazines by Aspergillus sclerotiorum. Mycologia 1969, 61, 452–467. [Google Scholar] [CrossRef]
- Moree, W.J.; Phelan, V.V.; Wu, C.-H.; Bandeira, N.; Cornett, D.S.; Duggan, B.M.; Dorrestein, P.C. Interkingdom metabolic transformations captured by microbial imaging mass spectrometry. Proc. Natl. Acad. Sci. USA 2012, 109, 13811–13816. [Google Scholar] [CrossRef] [PubMed]
- Chin-A-Woeng, T.F.; Thomas-Oates, J.E.; Lugtenberg, B.J.; Bloemberg, G.V. Introduction of the phzH gene of Pseudomonas chlororaphis PCL1391 extends the range of biocontrol ability of phenazine-1-carboxylic acid-producing Pseudomonas spp. strains. Mol. Plant-Microbe Interact. 2001, 14, 1006–1015. [Google Scholar] [CrossRef] [PubMed]
- Barbosa Coitinho, L.; Fumagalli, F.; da Rosa-Garzon, N.G.; da Silva Emery, F.; Cabral, H. Lapachol biotransformation by filamentous fungi yields bioactive quinone derivatives and lapachol-stimulated secondary metabolites. Prep. Biochem. Biotechnol. 2019, 49, 459–463. [Google Scholar] [CrossRef] [PubMed]
- de Matos, I.L.; Nitschke, M.; Porto, A.L.M. Regioselective and chemoselective biotransformation of 2′-hydroxychalcone derivatives by marine-derived fungi. Biocatal. Biotransform. 2023, 41, 46–56. [Google Scholar] [CrossRef]
- Wierckx, N.; Elink Schuurman, T.D.; Blank, L.M.; Ruijssenaars, H.J. Whole-cell biocatalytic production of 2, 5-furandicarboxylic acid. In Microorganisms in Biorefineries; Springer: Berlin/Heidelberg, Germany, 2014; pp. 207–223. [Google Scholar]
- Rajesh, R.O.; Godan, T.K.; Rai, A.K.; Sahoo, D.; Pandey, A.; Binod, P. Biosynthesis of 2, 5-furan dicarboxylic acid by Aspergillus flavus APLS-1: Process optimization and intermediate product analysis. Bioresour. Technol. 2019, 284, 155–160. [Google Scholar] [CrossRef]
- Deng, R.-X.; Yue, S.-J.; Wang, W.; Hu, H.-B.; Zhang, X.-H. Identification, biological evaluation, and improved biotransformation of a phenazine antioxidant using Streptomyces lomondensis S015 whole cells. Process Biochem. 2023, 125, 154–161. [Google Scholar] [CrossRef]
- Yue, S.J.; Song, C.; Li, S.; Huang, P.; Guo, S.Q.; Hu, H.B.; Wang, W.; Zhang, X.H. Synthesis of cinnabarinic acid by metabolically engineered Pseudomonas chlororaphis GP72. Biotechnol. Bioeng. 2019, 116, 3072–3083. [Google Scholar] [CrossRef]
- Klich, M.A. Identification of Common Aspergillus Species; CBS: New York, NY, USA, 2002. [Google Scholar]
- Schoch, C.L.; Seifert, K.A.; Huhndorf, S.; Robert, V.; Spouge, J.L.; Levesque, C.A.; Chen, W.; Consortium, F.B.; List, F.B.C.A.; Bolchacova, E. Nuclear ribosomal internal transcribed spacer (ITS) region as a universal DNA barcode marker for Fungi. Proc. Natl. Acad. Sci. USA 2012, 109, 6241–6246. [Google Scholar] [CrossRef]
- Raja, H.A.; Miller, A.N.; Pearce, C.J.; Oberlies, N.H. Fungal identification using molecular tools: A primer for the natural products research community. J. Nat. Prod. 2017, 80, 756–770. [Google Scholar] [CrossRef] [PubMed]
- Kumar, S.; Stecher, G.; Tamura, K. MEGA7: Molecular evolutionary genetics analysis version 7.0 for bigger datasets. Mol. Biol. Evol. 2016, 33, 1870–1874. [Google Scholar] [CrossRef] [PubMed]
- Zhang, X.; Gao, Y.; Yin, Y.; Cai, M.; Zhou, X.; Zhang, Y. Effective pH pretreatment and cell disruption method for real-time intracellular enzyme activity assay of a marine fungus covered with pigments. Prep. Biochem. Biotechnol. 2017, 47, 211–217. [Google Scholar] [CrossRef] [PubMed]
- Zhang, M.; Fan, D.; Su, C.; Pan, L.; He, Q.; Li, Z.; Liu, C. Biotransformation of sulfamethoxazole by a novel strain, Nitratireductor sp. GZWM139: Characterized performance, metabolic mechanism and application potential. J. Hazard. Mater. 2023, 441, 129861. [Google Scholar] [CrossRef]
- Supramani, S.; Jailani, N.; Ramarao, K.; Zain, N.A.M.; Klaus, A.; Ahmad, R.; Wan, W.A.A.Q.I. Pellet diameter and morphology of European Ganoderma pfeifferi in a repeated-batch fermentation for exopolysaccharide production. Biocatal. Agric. Biotechnol. 2019, 19, 101118. [Google Scholar] [CrossRef]
- Birhanli, E.; Yesilada, O. Increased production of laccase by pellets of Funalia trogii ATCC 200800 and Trametes versicolor ATCC 200801 in repeated-batch mode. Enzym. Microb. Technol. 2006, 39, 1286–1293. [Google Scholar] [CrossRef]
- Liu, Y.; Yue, S.; Bilal, M.; Jan, M.; Wang, W.; Hu, H.; Zhang, X. Development of Artificial Synthetic Pathway of Endophenazines in Pseudomonas chlororaphis P3. Biology 2022, 11, 363. [Google Scholar] [CrossRef] [PubMed]
- Peng, H.; Zhang, P.; Bilal, M.; Wang, W.; Hu, H.; Zhang, X. Enhanced biosynthesis of phenazine-1-carboxamide by engineered Pseudomonas chlororaphis HT66. Microb. Cell Factories 2018, 17, 117. [Google Scholar] [CrossRef]
- Hansen, G.M.; Laird, T.S.; Woertz, E.; Ojala, D.; Glanzer, D.; Ring, K.; Richart, S.M. Aspergillus sclerotiorum fungus is lethal to both Western drywood (Incisitermes minor) and Western subterranean (Reticulitermes hesperus) termites. Fine Focus 2016, 2, 23–38. [Google Scholar] [CrossRef]
- Zhou, Q.; Su, J.; Jiang, H.; Huang, X.; Xu, Y. Optimization of phenazine-1-carboxylic acid production by a gacA/qscR-inactivated Pseudomonas sp. M18GQ harboring pME6032Phz using response surface methodology. Appl. Microbiol. Biotechnol. 2010, 86, 1761–1773. [Google Scholar] [CrossRef]
- Kobayashi, M.; Nagasawa, T.; Yamada, H. Enzymatic synthesis of acrylamide: A success story not yet over. Trends Biotechnol. 1992, 10, 402–408. [Google Scholar] [CrossRef]
- Dejaegher, B.; Vander Heyden, Y. Ruggedness and robustness testing. J. Chromatogr. A 2007, 1158, 138–157. [Google Scholar] [CrossRef] [PubMed]
- Şahin, E. First green synthesis of (R)-2-methyl-1-phenylpropan-1-ol using whole-cell Lactobacillus paracasei BD101 biotransformation. Biocatal. Biotransform. 2020, 38, 138–143. [Google Scholar] [CrossRef]
- Salvi, N.A.; Chattopadhyay, S. Laboratory scale-up synthesis of chiral carbinols using Rhizopus arrhizus. Tetrahedron Asymmetry 2016, 27, 188–192. [Google Scholar] [CrossRef]
- Xiao, Z.; Lv, C.; Gao, C.; Qin, J.; Ma, C.; Liu, Z.; Liu, P.; Li, L.; Xu, P. A novel whole-cell biocatalyst with NAD+ regeneration for production of chiral chemicals. PLoS ONE 2010, 5, e8860. [Google Scholar] [CrossRef]
- de Oliveira, J.R.; Seleghim, M.H.R.; Porto, A.L.M. Biotransformation of methylphenylacetonitriles by Brazilian marine fungal strain Aspergillus sydowii CBMAI 934: Eco-friendly reactions. Mar. Biotechnol. 2014, 16, 156–160. [Google Scholar] [CrossRef]
- Şahin, E.; Serencam, H.; Dertli, E. Whole cell application of Lactobacillus paracasei BD101 to produce enantiomerically pure (S)-cyclohexyl (phenyl) methanol. Chirality 2019, 31, 211–218. [Google Scholar] [CrossRef]
- Yılmaz, D.; Şahin, E.; Dertli, E. Highly enantioselective production of chiral secondary alcohols using Lactobacillus paracasei BD 101 as a new whole cell biocatalyst and evaluation of their antimicrobial effects. Chem. Biodivers. 2017, 14, e1700269. [Google Scholar] [CrossRef] [PubMed]
- Şahin, E. Production of (R)-1-(1,3-benzodioxol-5-yl) ethanol in high enantiomeric purity by Lactobacillus paracasei BD 101. Chirality 2018, 30, 189–194. [Google Scholar] [CrossRef] [PubMed]
- Zilbeyaz, K.; Kurbanoglu, E.B.; Kilic, H. Preparation of Enantiomerically Pure (S)-(−)-1-(1’-naphthyl)-ethanol by the Fungus Alternaria alternata. Chirality 2016, 28, 669–673. [Google Scholar] [CrossRef]
- Parshikov, I.A.; Sutherland, J.B. Biotransformation of steroids and flavonoids by cultures of Aspergillus niger. Appl. Biochem. Biotechnol. 2015, 176, 903–923. [Google Scholar] [CrossRef] [PubMed]
- Parsons, J.F.; Greenhagen, B.T.; Shi, K.; Calabrese, K.; Robinson, H.; Ladner, J.E. Structural and functional analysis of the pyocyanin biosynthetic protein PhzM from Pseudomonas aeruginosa. Biochemistry 2007, 46, 1821–1828. [Google Scholar] [CrossRef] [PubMed]
- Lin, B.-X.; Zhang, Z.-J.; Liu, W.-F.; Dong, Z.-Y.; Tao, Y. Enhanced production of N-acetyl-D-neuraminic acid by multi-approach whole-cell biocatalyst. Appl. Microbiol. Biotechnol. 2013, 97, 4775–4784. [Google Scholar] [CrossRef] [PubMed]
- Knapp, J.S.; Zhang, F.m.; Tapley, K.N. Decolourisation of Orange II by a wood-rotting fungus. J. Chem. Technol. Biotechnol. Int. Res. Process Environ. Clean Technol. 1997, 69, 289–296. [Google Scholar] [CrossRef]
Disclaimer/Publisher’s Note: The statements, opinions and data contained in all publications are solely those of the individual author(s) and contributor(s) and not of MDPI and/or the editor(s). MDPI and/or the editor(s) disclaim responsibility for any injury to people or property resulting from any ideas, methods, instructions or products referred to in the content. |
© 2023 by the authors. Licensee MDPI, Basel, Switzerland. This article is an open access article distributed under the terms and conditions of the Creative Commons Attribution (CC BY) license (https://creativecommons.org/licenses/by/4.0/).